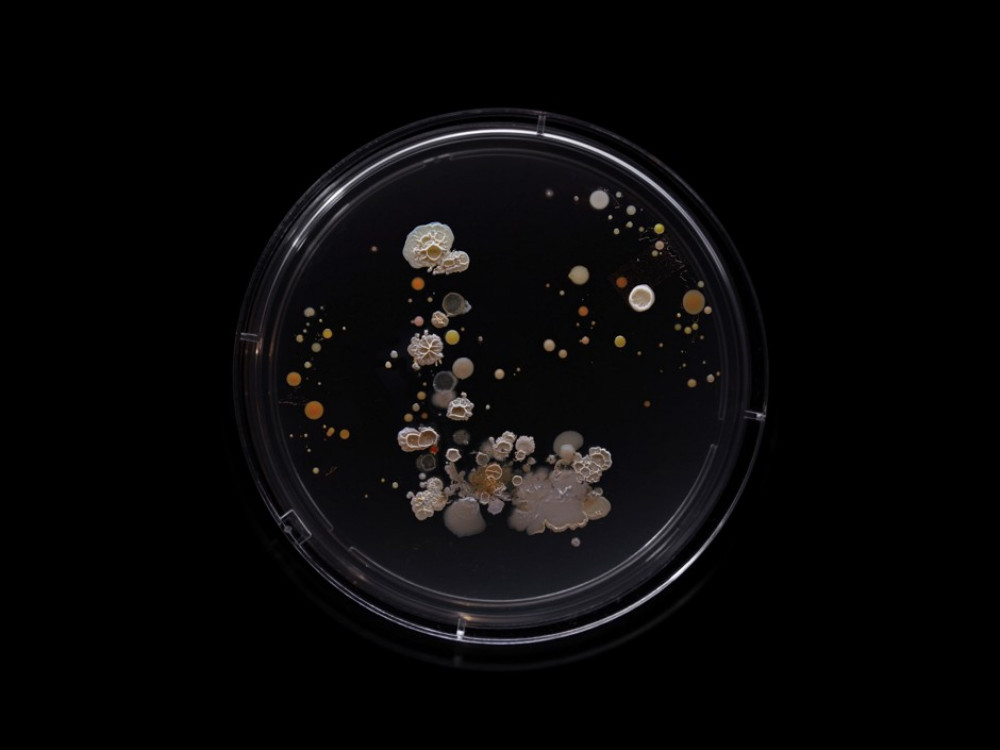
Zašto Japanom hara mesožderna bakterija i kako se zaštititi

Japan se suočava sa sve većim brojem slučajeva bolesti uzrokovanih rijetkim "mesoždernim bakterijama" koje ljude mogu ubiti unutar 48 sati.
Zdravstvene vlasti su početkom lipnja prijavile više od tisuću slučajeva sindroma toksičnog šoka uzrokovanog streptokokom (engl. streptococcal toxic shock syndrome – STSS), što je više od rekordnih 941 slučaja prijavljenih tijekom cijele 2023. godine. Stručnjaci strahuju da bi, pri trenutnoj stopi zaraze, broj slučajeva u Japanu ove godine mogao dosegnuti 2,5 tisuća.
Evo što trebate znati o ovoj bolesti.
Što je STSS?
Sindrom streptokoknog toksičnog šoka rijetka je, ali ozbiljna bakterijska infekcija koja se brzo može razviti u hitnu situaciju opasnu po život, prema japanskom Nacionalnom institutu za infektivne bolesti, koji prati pojavu ove bolesti od 1999. godine.
Što uzrokuje STSS?
Uzrokuju ga, između ostalih, Staphylococcus aureus ili Streptococcus pyogenes (poznat i kao streptokok grupe A, engl. group A Streptococcus – GAS), soj bakterija koji može izazvati oticanje i bol u grlu kod djece poznatije kao "streptokokno grlo". Međutim, ako se proširi u pacijentovo duboko tkivo i krvotok, simptomi se mogu brzo pogoršati.
Koliko je opasan?
Brzina kojom se bolest razvija najviše zabrinjava u vezi s STSS-om. Većina smrtnih slučajeva dogodi se unutar 48 sati od infekcije, prema Kenu Kikuchiju, profesoru zaraznih bolesti na Tokijskom ženskom medicinskom sveučilištu, ostavljajući liječnicima malo vremena da je identificiraju i liječe. Čak 30 posto ljudi s infekcijom će od nje umrijeti, kažu američki centri za kontrolu i prevenciju bolesti. Kikuchi opisuje stopu smrtnosti kao "zastrašujuću".
 Bloomberg
Bloomberg
Ipak, važno je napomenuti da su slučajevi i dalje rijetki, s brojem infekcija u Japanu daleko manjim od gripe ili COVID-a koji je ove godine do 9. lipnja zabilježen u 764 tisuće slučajeva, prema izvješćima iz pet tisuća bolnica. Japansko ministarstvo zdravstva savjetovalo je turiste da ne otkazuju planove putovanja zbog epidemije.
Koji su simptomi?
Prvi znaci STSS-a su slični gripi, kao što su groznica, bolovi u mišićima i mučnina. Međutim, unutar 48 sati stvari mogu postati mnogo ozbiljnije, pa pacijenti pate od niskog krvnog tlaka i ubrzanog otkucaja srca i disanja. Velike komplikacije infekcije su česte, kao što su zatajenje organa i šok.
Što je terapija?
To se ne može preboljeti odmaranjem kod kuće. Pacijentima je potrebna bolnička skrb, gdje tretmani uključuju intravenske tekućine za pomoć u borbi protiv šoka i zatajenja organa, kaže CDC. U ekstremnijim slučajevima, pacijentima će možda biti potrebna operacija za uklanjanje inficiranog tkiva.
Zašto postaje sve prisutniji u Japanu?
Ukratko, još uvijek ne znamo. Različite zarazne bolesti, uključujući gripu i adenovirus, povećale su se kada su ograničenja zbog COVID-a ublažena, kaže Kikuchi. Dok su slučajevi tih češćih infekcija na kraju opali, broj sindroma toksičnog šoka streptokoka ostao je relativno visok.
U međuvremenu, Velika Britanija, Francuska, Irska, Nizozemska i Švedska prijavile su porast invazivnih GAS infekcija, koje uključuju STSS, nakon što su ograničenja zbog COVID-a ublažena krajem 2022.
Kako spriječiti zarazu?
Rijetko netko s STSS-om infekciju prenese na druge, ali manje teške streptokokne infekcije su zaraznije i mogu se razviti u STSS. Mnogi koraci za sprječavanje infekcije odnose se na osnovnu higijenu. Često perite ruke, pokrivajte kašalj i kihanje, čistite i njegujte rane ili gljivične infekcije. Ako imate otvorenu ranu ili infekciju kože, CDC savjetuje da ne provodite vrijeme u bazenima, jezerima, rijekama ili oceanu ili u toplim kadama. Kod ozbiljnijih infekcija antibiotici mogu pomoći, posebno kod pacijenata starijih od 65 godina.

.png)